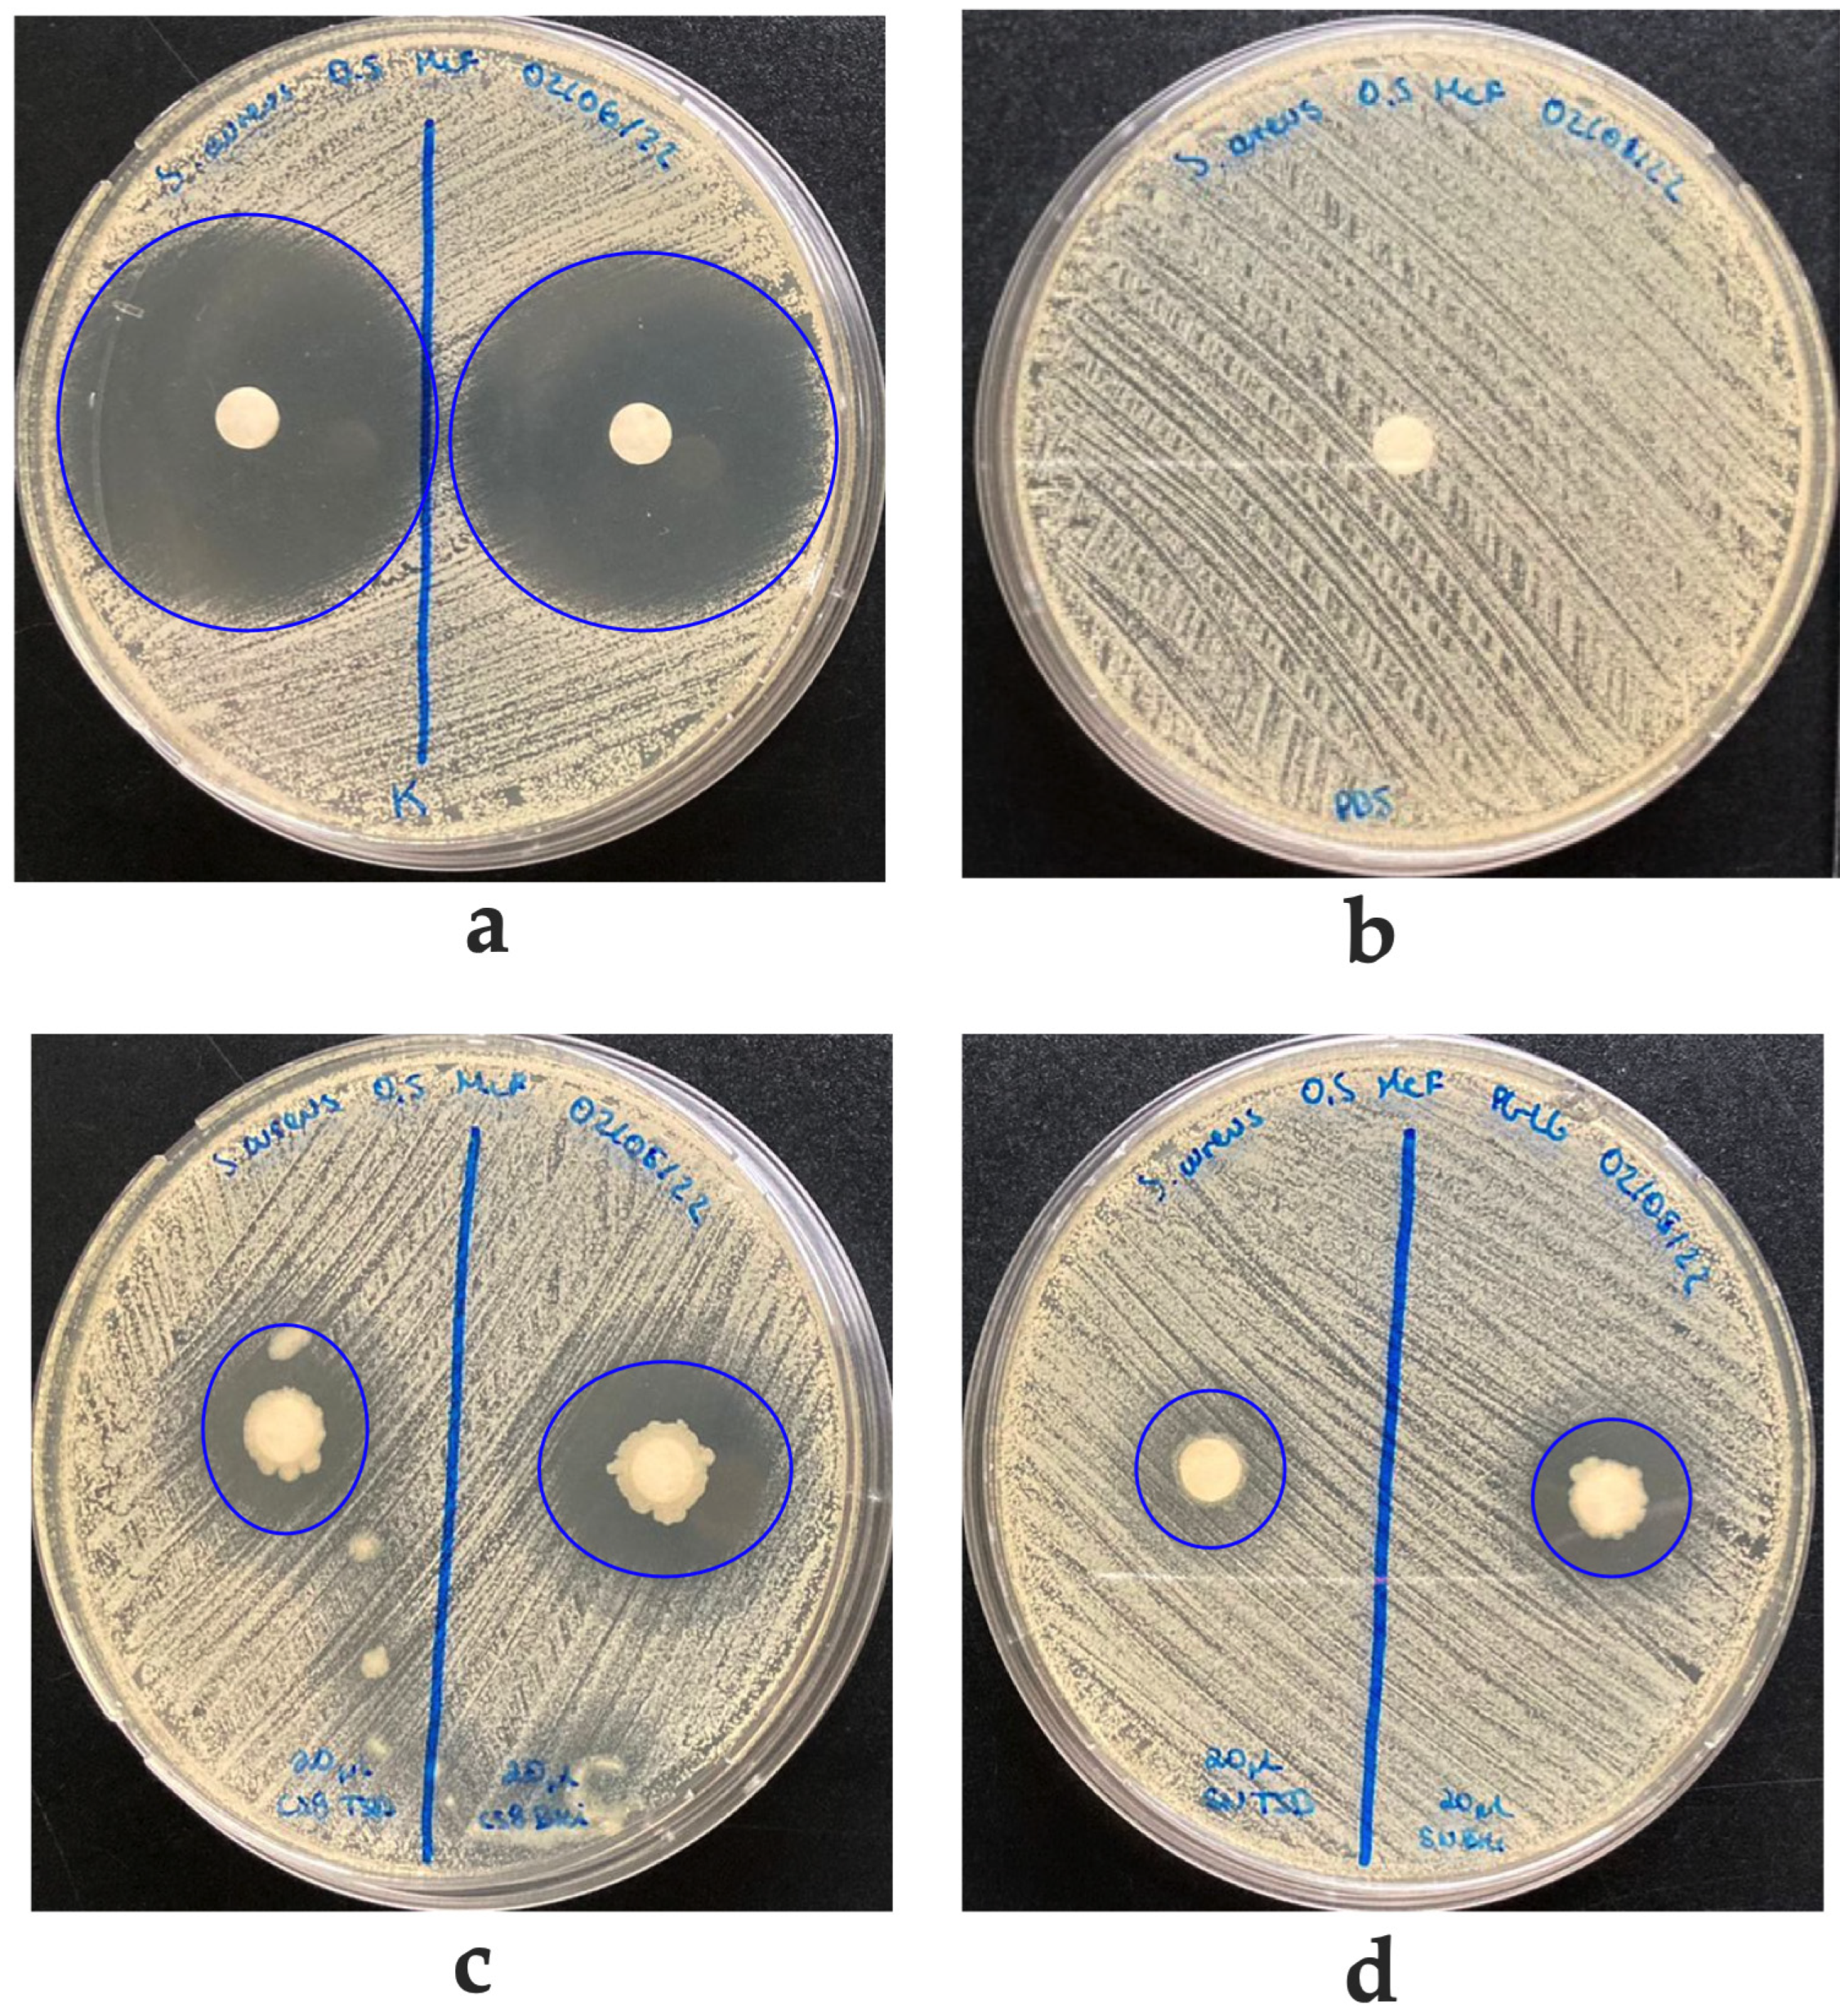
Biology 12 00920 g003 Biology 12 00920 g003

Diversity of Culturable Bacteria from Endemic Medicinal Plants of the Highlands of the Province of Parinacota, Chile
Abstract
Simple Summary
Abstract
1. Introduction
2. Materials and Methods
2.1. General
2.2. Bacterial Isolation
2.3. Genetic Bacterial Identification
2.3.1. Genomic DNA Extraction
2.3.2. Sequencing Genomic DNA
2.3.3. Phylogenetic Analysis
2.4. Bacterial Characterization
2.4.1. Gram Staining
2.4.2. In Vitro Detection of Hydrolytic Activities
2.4.3. In Vitro Plant-Growth-Promoting Traits
2.4.4. In Vitro Growth Inhibition of Phytopathogenic Fungi
2.4.5. In Vitro Growth Inhibition of Pathogenic Bacteria
2.4.6. Antimicrobial Activity of Supernatants from Bacteria
3. Results
3.1. Bacterial Isolation, Identification, Distribution, and Functional Characterization
3.2. Phylogenetic Analysis
4. Discussion
5. Conclusions
Supplementary Materials
Author Contributions
Funding
Institutional Review Board Statement
Informed Consent Statement
Data Availability Statement
Acknowledgments
Conflicts of Interest
References
- Hacquard, S.; Garrido-Oter, R.; González, A.; Spaepen, S.; Ackermann, G.; Lebeis, S.; McHardy, A.C.; Dangl, J.L.; Knight, R.; Ley, R.; et al. Microbiota and Host Nutrition across Plant and Animal Kingdoms. Cell Host Microbe 2015, 17, 603–616. [Google Scholar] [CrossRef]
- Dubey, A.; Malla, M.A.; Khan, F.; Chowdhary, K.; Yadav, S.; Kumar, A.; Sharma, S.; Khare, P.K.; Khan, M.L. Soil microbiome: A key player for conservation of soil health under changing climate. Biodivers. Conserv. 2019, 28, 2405–2429. [Google Scholar] [CrossRef]
- Calvo Vélez, P.; Reymundo Meneses, L.; Zúñiga Dávila, D. Estudio de las Poblaciones Microbianas de la Rizósfera del Cultivo de Papa (Solanum tuberosum) en Zonas Altoandinas. Ecol. Appl. 2008, 7, 141–148. Available online: http://www.scielo.org.pe/pdf/ecol/v7n1-2/a17v7n1-2.pdf (accessed on 19 December 2022). [CrossRef]
- Tse, C.; Ma, K. Growth and Metabolism of Extremophilic Microorganisms. In Biothechnology of Extremophiles; Rampelotto, P.H., Ed.; Springer: Cham, Switzerland, 2019; pp. 1–47. [Google Scholar]
- Azua-Bustos, A.; Caro-Lara, L.; Vicuña, R. Discovery and microbial content of the driest site of the hyperarid Atacama Desert, Chile. Environ. Microbiol. Rep. 2015, 7, 388–394. [Google Scholar] [CrossRef]
- Pacentini, R.D.; Cede, A.; Bárcena, H. Extreme solar total and UV irradiances due to cloud effect measured near the summer solstice at the high-altitude desertic plateau Puna of Atacama (Argentina). J. Atmos. Sol.-Terr. Phys. 2003, 65, 727–731. [Google Scholar] [CrossRef]
- McKay, C.P.; Friedmann, E.I.; Gómez-Silva, B.; Cáceres-Villanueva, L.; Andersen, D.T.; Landheim, R. Temperature and moisture conditions for life in the extreme arid region of the Atacama Desert: Four years of observations including the El Niño of 1997–1998. Astrobiology 2003, 3, 393–406. [Google Scholar] [CrossRef]
- Bull, A.T.; Asenjo, J.A.; Goodfellow, M.; Gómez-Silva, B. The Atacama Desert: Technical resources and the growing importance of novel microbial diversity. Annu. Rev. Microbiol. 2016, 70, 215–234. [Google Scholar] [CrossRef]
- Azua-Bustos, A.; Urrejola, C.; Vicuña, R. Life at the dry edge: Microorganisms of the Atacama Desert. FEBS Lett. 2012, 586, 2939–2945. [Google Scholar] [CrossRef] [PubMed]
- Dose, K.; Bieger-Dose, A.; Ernst, B.; Feister, U.; Gόmez-Silva, B.; Klein, A.; Risi, S.; Stridde, C. Survival of microorganisms under the extreme conditions of the Atacama Desert. Orig. Life Evol. Biosph. 2001, 31, 287–303. [Google Scholar] [CrossRef] [PubMed]
- Albarracin, V.H.; Kurth, D.; Ordoñez, O.; Belfiore, C.; Luccini, E.; Salum, G.M.; Piacentini, R.D.; Farías, M.E. High-Up: A Remote Reservoir of Microbial Extremophiles in Central Andean Wetlands. Front. Microbiol. 2015, 6, 1404. [Google Scholar] [CrossRef] [PubMed]
- DiRuggiero, J.; Wierzchos, J.; Robinson, C.K.; Souterre, T.; Ravel, J.; Artieda, O.; Souza-Egipsy, V.; Ascaso, C. Microbial colonization of chasmoendolithic habitats in the hyper-arid zone of the Atacama Desert. Biogeosciences 2013, 10, 2439–2450. [Google Scholar] [CrossRef]
- Maldonado, J.E.; Gaete, A.; Mandakovic, D.; Aguado-Norese, C.; Aguilar, M.; Gutierrez, R.A.; Gonzalez, M. Partners to survive: Hoffmannseggia doellii root-associated microbiome at the Atacama Desert. New Phytol. 2022, 234, 2126–2139. [Google Scholar] [CrossRef]
- Stivaletta, N.; Barbieri, R.; Cevenini, F.; López-García, P. Physicochemical Conditions and Microbial Diversity Associated with the Evaporite Deposits in the Laguna de la Piedra (Salar de Atacama, Chile). Geomicrobiol. J. 2011, 28, 83–95. [Google Scholar] [CrossRef]
- Araya, J.P.; Gonzalez, M.; Cardinale, M.; Schnell, S.; Stoll, A. Microbiome Dynamics Associated with the Atacama Flowering Desert. Front. Microbiol. 2020, 10, 3160. [Google Scholar] [CrossRef]
- Contador, C.A.; Veas-Castillo, L.; Tapia, E.; Antipán, M.; Miranda, N.; Ruiz-Tagle, B.; García-Araya, J.; Andrews, B.A.; Marin, M.; Dorador, C.; et al. Atacama Database: A platform of the microbiome of the Atacama Desert. Antonie Leeuwenhoek 2020, 113, 185–195. [Google Scholar] [CrossRef]
- Fuentes, A.; Herrera, H.; Charles, T.C.; Arriagada, C. Fungal and Bacterial Microbiome Associated with the Rhizosphere of Native Plants from the Atacama Desert. Microorganisms 2020, 8, 209. [Google Scholar] [CrossRef]
- Maza, F.; Maldonado, J.; Vásquez-Dean, J.; Mandakovic, D.; Gaete, A.; Cambiazo, V.; González, M. Soil Bacterial Communities from the Chilean Andean Highlands: Taxonomic Composition and Culturability. Front. Bioeng. Biotechnol. 2019, 7, 10. [Google Scholar] [CrossRef] [PubMed]
- Dorador, C.; Vila, I.; Witzel, P.; Imhoff, J. Bacterial and arqueal diversity in high altitude wetlands of the Chilean Altiplano. Fundam. Appl. Limnol. 2013, 182, 135–159. [Google Scholar] [CrossRef]
- Muñoz, P.A.; Arismendi, M.J.; Cárdenas, S.F.; Cifuentes-Bachmann, D.E.; Venegas, F.A.; Sepúlveda-Chavera, G.F. Diversity of culturable bacteria isolated from ancestral crops of Arica and Parinacota Region, Atacama Desert. Antonie Leeuwenhoek 2020, 113, 2123–2137. [Google Scholar] [CrossRef] [PubMed]
- Fernández-Gómez, B.; Maldonado, J.; Mandakovic, D.; Gaete, A.; Gutiérrez, R.A.; Maass, A.; Cambiazo, V.; González, M. Bacterial communities associated to Chilean altiplanic native plants from the Andean grassland soils. Sci. Rep. 2019, 9, 1042. [Google Scholar] [CrossRef] [PubMed]
- Gómez-Silva, B.; Rainey, F.A.; Warren-Rhodes, K.A.; McKay, C.P.; Navarro-González, R. Atacama Desert Soil Microbiology. In Microbiology of Extreme Soils; Dion, P., Nautiyal, C.S., Eds.; Springer: Berlin/Heidelberg, Germany, 2008. [Google Scholar] [CrossRef]
- Navarro-Gonzalez, R.; Iniguez, E.; de la Rosa, J.; McKay, C.P. Characterization of organics, microorganisms, Desert soils, and mars-like soils by thermal volatilization coupled to mass spectrometry and their implications for the search for organics on mars by phoenix and future space missions. Astrobiology 2009, 9, 703–715. [Google Scholar] [CrossRef]
- Rateb, M.E.; Houssen, W.E.; Arnold, M.; Abdelrahman, M.H.; Deng, H.; Harrison, W.T.A.; Okoro, C.K.; Asenjo, J.A.; Andrews, B.A.; Ferguson, G.; et al. Chaxamycins A–D, Bioactive Ansamycins from a Hyper-arid desert Streptomyces sp. J. Nat. Prod. 2011, 74, 1491–1499. [Google Scholar] [CrossRef] [PubMed]
- Castro, J.F.; Razmilic, V.; Gomez-Escribano, J.P.; Andrews, B.; Asenjo, J.; Bibb, M. The ‘gifted’ actinomycete Streptomyces leeuwenhoekii. Antonie Leeuwenhoek 2018, 111, 1433–1448. [Google Scholar] [CrossRef] [PubMed]
- Jo, J.H.; Kennedy, E.A.; Kong, H.H. Research Techniques Made Simple: Bacterial 16S Ribosomal RNA Gene Sequencing in Cutaneous Research. J. Investig. Dermatol. 2016, 136, e23–e27. [Google Scholar] [CrossRef]
- Wang, Y.; Qian, P.Y. Conservative fragments in bacterial 16S rRNA genes and primer design for 16S ribosomal DNA amplicons in metagenomic studies. PLoS ONE 2009, 9, e7401. [Google Scholar] [CrossRef] [PubMed]
- Caporaso, J.G.; Lauber, C.L.; Walters, W.A.; Berg-Lyons, D.; Lozupone, C.A.; Turnbaugh, P.J.; Fierer, N.; Knight, R. Global patterns of 16S rRNA diversity at a depth of millions of sequences per sample. Proc. Natl. Acad. Sci. USA 2011, 108, 4516–4522. [Google Scholar] [CrossRef]
- Villagrán, C.; Romo, M.; Castro, V. Etnobotánica del sur de los andes de la primera región de Chile: Un enlace entre las culturas altiplánicas y las de quebradas altas del Loa superior. Chungará 2003, 35, 73–124. [Google Scholar] [CrossRef]
- Altschul, S.; Gish, W.; Miller, W.; Myers, E.; Lipman, D. Basic local alignment search tool. J. Mol. Biol. 1990, 215, 403–410. [Google Scholar] [CrossRef]
- Thompson, J.D.; Higgins, D.G.; Gibson, T.J. CLUSTAL W: Improving the sensitivity of progressive multiple sequence alignment through sequence weighting, position-specific gap penalties and weight matrix choice. Nucleic Acids Res. 1994, 22, 4673–4680. [Google Scholar] [CrossRef]
- Kumar, S.; Stecher, G.; Tamura, K. MEGA7: Molecular Evolutionary Genetics Analysis version 7.0 for bigger datasets. Mol. Biol. Evol. 2016, 33, 1870–1874. [Google Scholar] [CrossRef]
- Waterhouse, A.M.; Procter, J.B.; Martin, D.M.A.; Clamp, M.; Barton, G.J. Jalview Version 2-a multiple sequence alignment editor and analysis workbench. Bioinformatics 2009, 25, 1189–1191. [Google Scholar] [CrossRef] [PubMed]
- Beveridge, T.J. Use of the gram stain in microbiology. Biotech. Histochem. 2001, 76, 111–118. [Google Scholar] [CrossRef] [PubMed]
- Hossain, T.J.; Chowdhury, S.I.; Mozumder, H.A.; Chowdhury, M.N.A.; Ali, F.; Rahman, N.; Dey, S. Hydrolytic Exoenzymes Produced by Bacteria Isolated and Identified from the Gastrointestinal Tract of Bombay Duck. Front. Microbiol. 2020, 11, 2097. [Google Scholar] [CrossRef]
- Bhowmik, S.; Islam, S.; Ahmed, M.M.; Hossain, M.B.; Hossain, M.A. Protease Producing Bacteria and Activity in Gut of Tiger Shrimp (Penaeus monodon). J. Fish. Aquat. Sci. 2015, 10, 489–500. [Google Scholar] [CrossRef]
- Slifkin, M. Tween 80 opacity test responses of various Candida species. J. Clin. Microbiol. 2000, 38, 4626–4628. [Google Scholar] [CrossRef]
- Ehmann, A. The Van Urk-Salkowski reagent-a sensitive and specific chromogenic reagent for silica gel thin-layer chromatographic detection and identification of indole derivatives. J. Chromatogr. 1977, 132, 267–276. [Google Scholar] [CrossRef]
- Schwynand, B.; Neilands, J. Universal chemical assay for the detection and determination of siderophores. Anal. Biochem. 1987, 160, 47–56. [Google Scholar] [CrossRef]
- Pikovskaya, R. Mobilization of phosphorus in soil in connection with the vital activity of some microbial species. Mikrobiologiya 1948, 17, 362–370. [Google Scholar]
- Rodríguez, E. Improved medium for isolation of Azospirillum spp. Appl. Environ. Microbiol. 1982, 44, 990–991. [Google Scholar] [CrossRef]
- Sepúlveda-Chavera, G.F.; Arismendi, M.; Muñoz-Torres, P. Endospore-Forming Bacteria Present in a Commercial Stabilized Poultry Manure Determines the Fusarium Biocontrol and the Tomato Growth Promotion. Agronomy 2020, 10, 1636. [Google Scholar] [CrossRef]
- CLSI. Autoverification of Medical Laboratory Results for Specific Disciplines, 1st ed.; CLSI guideline AUTO15; Clinical and Laboratory Standards Institute: Wayne, PA, USA, 2019; Available online: https://clsi.org/standards/products/automation-and-informatics/documents/auto15/ (accessed on 22 July 2022).
- Morales, G.; Paredes, A.; Sierra, P.; Loyola, L.A. Antimicrobial activity of three Baccharis species used in the traditional medicine of Northern Chile. Molecules 2008, 13, 790–794. [Google Scholar] [CrossRef] [PubMed]
- Hibbing, M.E.; Fuqua, C.; Parsek, M.R.; Peterson, S.B. Bacterial competition: Surviving and thriving in the microbial jungle. Nat. Rev. Microbiol. 2010, 8, 15–25. [Google Scholar] [CrossRef]
- Wu, G.; Chen, Z.; Jiang, D.; Jiang, N.; Jiang, H.; Chen, L. Oxidases and hydrolases mediate soil organic matter accumulation in chernozem of northeastern China. Geoderma 2021, 403, 115206. [Google Scholar] [CrossRef]
- Dogan, G.; Taskin, B. Hydrolytic Enzymes Producing Bacterial Endophytes of Some Poaceae Plants. Pol. J. Microbiol. 2021, 70, 297–304. [Google Scholar] [CrossRef] [PubMed]
- Jalgaonwala, R.E.; Mahajan, R.T. Evaluation of hydrolytic enzyme activities of endophytes from some indigenous medicinal plants. Int. J. Agric. Technol. 2011, 7, 1733–1741. Available online: https://www.thaiscience.info/journals/Article/IJAT/10841194.pdf (accessed on 16 June 2023).
- Crits-Christoph, A.; Robinson, C.K.; Barnum, T.; Fricke, W.F.; Davila, A.F.; Jedynak, B.; McKay, C.P.; DiRuggiero, J. Colonization patterns of soil microbial communities in the Atacama Desert. Microbiome 2013, 1, 28. [Google Scholar] [CrossRef] [PubMed]
- Gaete, A.; Andreani-Gerard, C.; Maldonado, J.E.; Muñoz-Torres, P.A.; Sepúlveda-Chavera, G.F.; González, M. Bioprospecting of Plant Growth-Promoting Traits of Pseudomonas sp. Strain C3 Isolated from the Atacama Desert: Molecular and Culture-Based Analysis. Diversity 2022, 14, 388. [Google Scholar] [CrossRef]
- Jones, P.; Garcia, B.J.; Furches, A.; Tuskan, G.A.; Jacobson, D. Plant Host-Associated Mechanisms for Microbial Selection. Front. Plant Sci. 2019, 10, 862. [Google Scholar] [CrossRef]
- Gopal, M.; Gupta, A. Microbiome Selection Could Spur Next-Generation Plant Breeding Strategies. Front. Microbiol. 2016, 7, 1971. [Google Scholar] [CrossRef]
- Schmidt, J.E.; Kent, A.D.; Brisson, V.L.; Gaudin, A.C.M. Agricultural management and plant selection interactively affect rhizosphere microbial community structure and nitrogen cycling. Microbiome 2019, 7, 146. [Google Scholar] [CrossRef]
- Nwachukwu, B.; Ayangbenro, A.; Babalola, O. Elucidating the Rhizosphere Associated Bacteria for Environmental Sustainability. Agriculture 2021, 11, 75. [Google Scholar] [CrossRef]
- Mishra, P.; Mishra, J.; Dwivedi, S.; Arora, N. Microbial Enzymes in Biocontrol of Phytopathogens. In Microbial Enzymes: Roles and Applications in Industries; Arora, N.K., Mishra, J., Mishra, V., Eds.; Microorganisms for Sustainability; Springer: Singapore, 2020; pp. 259–285. [Google Scholar] [CrossRef]
- Narasimha-Murthy, K.; Soumya, K.; Udayashankar, A.C.; Sudisha-Jogaiah, S.C. Biocontrol potential of plant growth-promoting rhizobacteria (PGPR) against Ralstonia solanacearum: Current and future prospects. In Biocontrol Agents and Secondary Metabolites; Woodhead Publishing: Sawston, UK, 2021; pp. 153–180. [Google Scholar] [CrossRef]
- Majumdar, S.; Chakraborty, U. Optimization of protease production from plant growth promoting Bacillus amyloliquefaciens showing antagonistic activity against phytopathogens. Int. J. Pharm. Bio Sci. 2017, 8, 635–642. [Google Scholar] [CrossRef]
- Gupta, R.; Gupta, N.; Rathi, P. Bacterial lipases: An overview of production, purification and biochemical properties. Appl. Microbiol. Biotechnol. 2004, 64, 763–781. [Google Scholar] [CrossRef] [PubMed]
- Kim, H.K.; Choi, H.J.; Kim, M.H.; Sohn, C.B.; Oh, T.K. Expression and characterization of Ca2+-independent lipase from Bacillus pumilus B26. BBA Mol. Cell Biol. Lipids 2002, 1583, 205–212. [Google Scholar] [CrossRef] [PubMed]
- Chandra, P.; Enespa; Singh, R.; Arora, P.K. Microbial lipases and their industrial applications: A comprehensive review. Microb. Cell Fact. 2020, 19, 169. [Google Scholar] [CrossRef]
- Arifin, A.R.; Kim, S.J.; Yim, J.H.; Suwanto, A.; Kim, H.K. Isolation and biochemical characterization of Bacillus pumilus lipases from the Antarctic. J. Microbiol. Biotechnol. 2013, 23, 661–667. [Google Scholar] [CrossRef] [PubMed]
- Kumar, R.; Sharma, A.; Kumar, A.; Singh, D. Lipase from Bacillus pumilus RK31: Production, Purification and Some Properties. World Appl. Sci. J. 2012, 16, 940–948. Available online: https://www.idosi.org/wasj/wasj16(7)12/8.pdf (accessed on 28 February 2023).
- Wu, H.; Gu, Q.; Xie, Y.; Lou, Z.; Xue, P.; Fang, L.; Yu, C.; Jia, D.; Huang, G.; Zhu, B.; et al. Cold-adapted Bacilli isolated from the Qinghai–Tibetan Plateau are able to promote plant growth in extreme environments. Environ. Microbiol. 2019, 21, 3505–3526. [Google Scholar] [CrossRef]
- Koza, N.A.; Adedayo, A.A.; Babalola, O.O.; Kappo, A.P. Microorganisms in Plant Growth and Development: Roles in Abiotic Stress Tolerance and Secondary Metabolites Secretion. Microorganisms 2022, 10, 1528. [Google Scholar] [CrossRef]
- Wang, L.; Chen, M.; Lam, P.Y.; Dini-Andreote, F.; Dai, L.; Wei, Z. Multifaceted roles of flavonoids mediating plant-microbe interactions. Microbiome 2022, 10, 233. [Google Scholar] [CrossRef]
- Saggese, A.; De Luca, Y.; Baccigalupi, L.; Ricca, E. An antimicrobial peptide specifically active against Listeria monocytogenes is secreted by Bacillus pumilus SF214. BMC Microbiol. 2022, 22, 3. [Google Scholar] [CrossRef]
- Tran, C.; Cock, I.E.; Chen, X.; Feng, Y. Antimicrobial Bacillus: Metabolites and Their Mode of Action. Antibiotics 2022, 12, 88. [Google Scholar] [CrossRef]
- Caulier, S.; Nannan, C.; Gillis, A.; Licciardi, F.; Bragard, C.; Mahillon, J. Overview of the Antimicrobial Compounds Produced by Members of the Bacillus subtilis Group. Front. Microbiol. 2019, 10, 302. [Google Scholar] [CrossRef]
- Castronovo, L.M.; Vassallo, A.; Mengoni, A.; Miceli, E.; Bogani, P.; Firenzuoli, F.; Fani, R.; Maggini, V. Medicinal Plants and Their Bacterial Microbiota: A Review on Antimicrobial Compounds Production for Plant and Human Health. Pathogens 2021, 10, 106. [Google Scholar] [CrossRef]
- Jasim, B.; Sreelakshmi, S.; Mathew, J.; Radhakrishnan, E.K. Identification of endophytic Bacillus mojavensis with highly specialized broad-spectrum antibacterial activity. 3 Biotech 2016, 6, 187. [Google Scholar] [CrossRef]
- Roy, S.; Yasmin, S.; Ghosh, S.; Bhattacharya, S.; Banerjee, D. Anti-Infective Metabolites of a Newly Isolated Bacillus thuringiensis KL1 Associated with Kalmegh (Andrographis paniculata Nees.), a Traditional Medicinal Herb. Microbiol. Insights 2016, 9, 1–7. [Google Scholar] [CrossRef]
- Castillo, U.F.; Strobel, G.A.; Ford, E.J.; Hess, W.M.; Porter, H.; Jensen, J.B.; Albert, H.; Robison, R.; Condron, M.A.M.; Teplow, D.B.; et al. Munumbicins, wide-spectrum antibiotics produced by Streptomyces NRRL 30562, endophytic on Kennedia nigriscans. Microbiology 2002, 148, 2675–2685. [Google Scholar] [CrossRef] [PubMed]
- Maela, M.P.; van der Walt, H.; Serepa-Dlamini, M.H. The Antibacterial, Antitumor Activities, and Bioactive Constituents’ Identification of Alectra sessiliflora Bacterial Endophytes. Front. Microbiol. 2022, 13, 870821. [Google Scholar] [CrossRef] [PubMed]
- Conti, R.; Chagas, F.O.; Caraballo-Rodriguez, A.M.; Melo, W.G.; do Nascimento, A.; Cavalcanti, B.C.; de Moraes, M.O.; Pessoa, C.; Costa-Lotufo, L.V.; Krogh, R.; et al. Endophytic Actinobacteria from the Brazilian Medicinal Plant Lychnophora ericoides Mart. and the Biological Potential of Their Secondary Metabolites. Chem. Biodivers. 2016, 13, 727. [Google Scholar] [CrossRef] [PubMed]

| Site | Common Name | Scientific Name | Voucher N° | Latitude °S | Longitude °W | Altitude (m.a.s.l.) |
|---|---|---|---|---|---|---|
| 1 | Sallika | Rosmarinus officinalis | HRU1100 | 18.0810 | 69.5192 | 4888 |
| 2 | Jakana | Xenophyllum lycopodioides | HRU1101 | 18.0859 | 69.5234 | 5104 |
| 3 | Pura-Pura | Xenophyllum poposum | HRU1102 | 18.0842 | 69.5271 | 4951 |
| 4 | Pura-Pura | Xenophyllum poposum | HRU1102 | 18.0876 | 69.5294 | 4867 |
| 5 | Siputula | Parastrephia cuadrangularis | HRU1104 | 18.0873 | 69.5332 | 4807 |
| 6 | Chachacoma | Senecio nutans Sch. Bip | HRU1105 | 18.0897 | 69.5371 | 4789 |
| 7 | Noa-Tola | Parastrephia lucida | HRU1106 | 18.0957 | 69.5370 | 4830 |
| 8 | Chaka-Tola | Baccharis boliviensis | HRU1107 | 18.2061 | 69.5533 | 3686 |
| 9 | Llareta | Laretia acaulis | HRU1108 | 18.2079 | 69.5507 | 3683 |
| 10 | Yara | Dunalia spinosa | HRU1109 | 18.2084 | 69.5475 | 3681 |
| Activity | N° Isolates with Positive Reaction | Relative Frequency (%) |
|---|---|---|
| Protease | 28 | 71.8 |
| Lipase | 9 | 23.1 |
| Cellulase | 13 | 33.3 |
| Amylase | 22 | 56.4 |
| Auxin production | 4 | 10.3 |
| Siderophores production | 14 | 35.9 |
| N2 fixation Phosphate solubilization | 9 | 23.1 |
| 26 | 66.7 | |
| Botrytis cinerea * | 1 | 2.6 |
| Fusarium oxysporum * | 1 | 2.6 |
| Geotrichum candidum * | 0 | 0.0 |
| Phytium sp. * | 0 | 0.0 |
| Macrophomina phaseolina * | 6 | 15.4 |
| Monilinia fructicola * | 6 | 15.4 |
Disclaimer/Publisher’s Note: The statements, opinions and data contained in all publications are solely those of the individual author(s) and contributor(s) and not of MDPI and/or the editor(s). MDPI and/or the editor(s) disclaim responsibility for any injury to people or property resulting from any ideas, methods, instructions or products referred to in the content. |
© 2023 by the authors. Licensee MDPI, Basel, Switzerland. This article is an open access article distributed under the terms and conditions of the Creative Commons Attribution (CC BY) license (https://creativecommons.org/licenses/by/4.0/).
Share and Cite
Moraga, D.; Latorre, K.; Muñoz-Torres, P.; Cárdenas, S.; Jofré-Quispe, A.; López-Cepeda, J.; Bustos, L.; Balada, C.; Argaluza, M.F.; González, P.; et al. Diversity of Culturable Bacteria from Endemic Medicinal Plants of the Highlands of the Province of Parinacota, Chile. Biology 2023, 12, 920. https://doi.org/10.3390/biology12070920
Moraga D, Latorre K, Muñoz-Torres P, Cárdenas S, Jofré-Quispe A, López-Cepeda J, Bustos L, Balada C, Argaluza MF, González P, et al. Diversity of Culturable Bacteria from Endemic Medicinal Plants of the Highlands of the Province of Parinacota, Chile. Biology. 2023; 12(7):920. https://doi.org/10.3390/biology12070920
Chicago/Turabian StyleMoraga, Daniel, Katina Latorre, Patricio Muñoz-Torres, Steffany Cárdenas, Alan Jofré-Quispe, José López-Cepeda, Luis Bustos, Cristóbal Balada, María Fernanda Argaluza, Pablo González, and et al. 2023. "Diversity of Culturable Bacteria from Endemic Medicinal Plants of the Highlands of the Province of Parinacota, Chile" Biology 12, no. 7: 920. https://doi.org/10.3390/biology12070920
APA StyleMoraga, D., Latorre, K., Muñoz-Torres, P., Cárdenas, S., Jofré-Quispe, A., López-Cepeda, J., Bustos, L., Balada, C., Argaluza, M. F., González, P., & Guzmán, L. (2023). Diversity of Culturable Bacteria from Endemic Medicinal Plants of the Highlands of the Province of Parinacota, Chile. Biology, 12(7), 920. https://doi.org/10.3390/biology12070920

